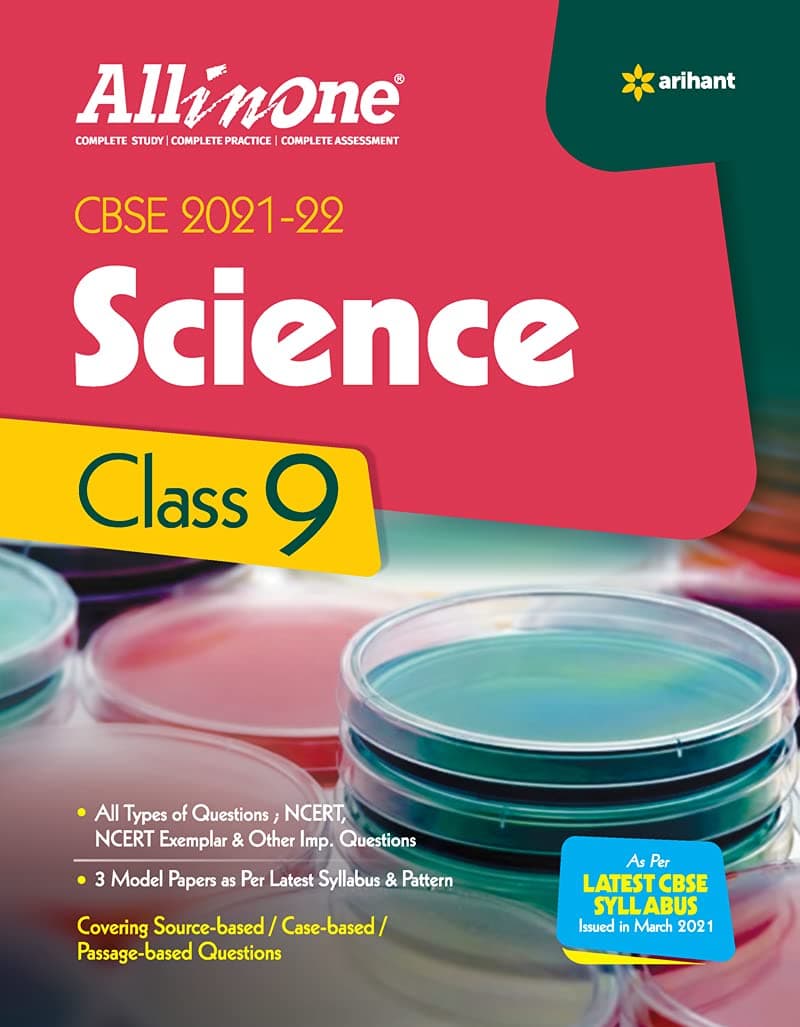
CBSE All In One Science Class 9 for 2022 Exam (Old Edition)

CBSE All In One Science Class 9 for 2022 Exam (Old Edition)
A**H
CBSE science book
Very nice book for the point of exam preparation.
J**N
Good
Good
S**H
Good Book
Book is good, pages could have been more good
S**A
Superb book for 9th graders
If you are in doubt to purchase this or not.!Then go for it.....it is too good...This book contains a short explanation with important paragraph and additional things...this book covers the ncert syllabus in a easy language to ease our syllabus...this book also have a variety of questions with their answersEach chapter contains more than 80 questionsThanks arihant ❤️
W**S
It helps me very much now i am more interested in science
It helps me very much now i am more interested in science
M**R
Good one
Good one
R**L
Best book for class 9
Best
M**T
It's good experience
It's very helpful to the students so thank you Amazon service
Trustpilot
2 days ago
5 days ago
1 month ago
1 week ago